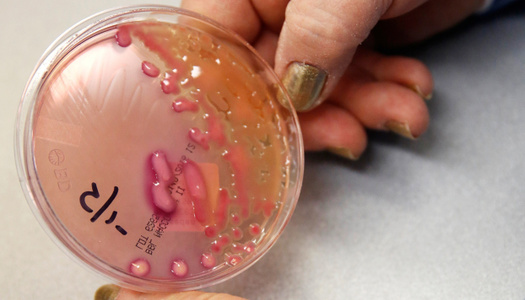

Американка умерла из-за инфекции, вызванной супербактерией. Что это значит?
Мы рассказываем честно не только про войну. Скачайте приложение.
В середине января стало известно, что в США у 70-летней женщины (ее имя не разглашается) обнаружили инфекцию, вызванную супербактерией Klebsiella pneumoniae. У пациентки развился сепсис (заражение крови), она умерла. Врачи не смогли спасти женщину, потому что бактерия оказалась устойчива к 26 антибиотикам, в том числе к антибиотику «последнего резерва» колистину. «Медуза» рассказывает об этом и других похожих случаях и о том, как наука может противостоять новой опасности.
Смерть от супербактерии — важная и пугающая новость. Бактерии, устойчивые сразу к нескольким антибиотикам, вызывают десятки, если не сотни тысяч смертей в год. Но среди этих микроорганизмов не так много тех, что устойчивы даже к антибиотикам «последнего резерва», то есть к определенным препаратам, приберегаемым врачами на самый крайний случай.
До последнего времени во многих случаях спасал колистин — антибиотик, который борется с грамотрицательными бактериями. Он нередко вызывает серьезные нежелательные реакции вроде повреждения почек, поэтому врачи в повседневной практике его не используют. Но используют фермеры: благодаря тому, что колистин постоянно подмешивают в еду свиньям, животные реже болеют и лучше растут. Из-за использования лекарства у бактерий появляется возможность приспособиться к такому антибиотику, а затем заразить человека или передать этот ген устойчивости другим бактериям, которые способны вызвать инфекции у людей. По всей видимости, именно так появились некоторые устойчивые к колистину бактерии. Раньше было известно, что такие микроорганизмы имеют ген MCR-1, который и делает их устойчивыми, но у бактерии, найденной у американской пациентки, такого гена нет. То есть ученые не знают, чем именно вызвана такая устойчивость, — им это только предстоит выяснить.
Американка могла заразиться в индийской клинике — там хорошие условия для супербактерий. Пациентка попала в больницу в Индии с переломом ноги. Больницы — удобное место для развития супербактерий. В стационарах лежит много людей, которые принимают разные антибиотики, и бактерии мутируют таким образом, чтобы противостоять препаратам. Индийские больницы — еще удобнее, потому что в этой стране многие люди живут в антисанитарных условиях и часто болеют бактериальными инфекциями. И не все клиники справляются с контролем распространения таких болезней.
Кризис эры антибиотиков предсказывали давно. Уже через несколько лет после начала применения первого антибиотика стало ясно, что в конце концов они могут стать бессильны перед бактериями. Сейчас, по всей видимости, стандартные пути получения антибиотиков исчерпаны. Раньше ученые могли выяснить, с помощью каких веществ защищаются грибы и бактерии, и использовать их в качестве лекарств. Со временем стало понятно, что искусственно можно вырастить только один процент из всех существующих бактерий. Соответственно, неизвестно, с помощью каких веществ остальные 99 процентов бактерий борются друг с другом. А раз так — нет возможности применить их методы защиты.
У ученых есть много идей, как справиться с проблемой устойчивости бактерий к антибиотикам. Одна из них — научиться выращивать эти 99 процентов бактерий и исследовать вещества, с помощью которых они воюют друг с другом. Эту задачу решил американский ученый Слава Эпштейн со своей командой. Они нашли несколько удачных химических соединений, и как минимум к одному из них даже в лабораторных условиях ни одна исследуемая бактерия не смогла выработать устойчивость.
Другой вариант — искать соединения в растениях. Кроме того, ведутся исследования: например, различных антител, бактериофагов и, что интересно, пробиотиков, то есть «хороших» бактерий. Однако в целом этот рынок не кажется фармкомпаниям привлекательным (с финансовой точки зрения куда интереснее разрабатывать лекарства от хронических заболеваний), поэтому их нужно как-то стимулировать, и для этого разрабатываются разнообразные стратегии — в основном всевозможные льготы для создателей препаратов, борющихся с бактериями.
Организации здравоохранения призывают сократить использование антибиотиков. Поскольку пока неизвестно, когда удастся найти способ побороть устойчивость супербактерий к антибиотикам, сейчас международные и национальные организации призывают сократить использование антибиотиков, чтобы у бактерий было меньше шансов приспособиться. Например, отказаться от препаратов тогда, когда они точно не нужны.
Проблема, правда, в том, что более хорошим среди пациентов обычно считается тот врач, который назначает «настоящее лечение» — антибиотики, а не предлагает просто справляться с симптомами, потому что у человека вирусная инфекция и специфической терапии нет. При этом известно, что антибиотики не борются с вирусами и, например, при ОРВИ от них точно больше вреда, чем пользы. Кроме того, по современным рекомендациям иногда даже бактериальные заболевания необязательно сразу лечить антибиотиками — нередко организм справляется с инфекцией сам, и к лекарствам можно прибегать, только если состояние ухудшилось.
Другой важный шаг — запрет на использование антибиотиков в сельском хозяйстве не для лечения. При этом важно заниматься профилактикой бактериальных инфекций и у животных, и у людей, но без использования антибиотиков. Например, распространять известные прививки и создавать новые; соблюдать элементарные правила гигиены в быту и следить за исполнением всех гигиенических предосторожностей в больницах.
Дарья Саркисян